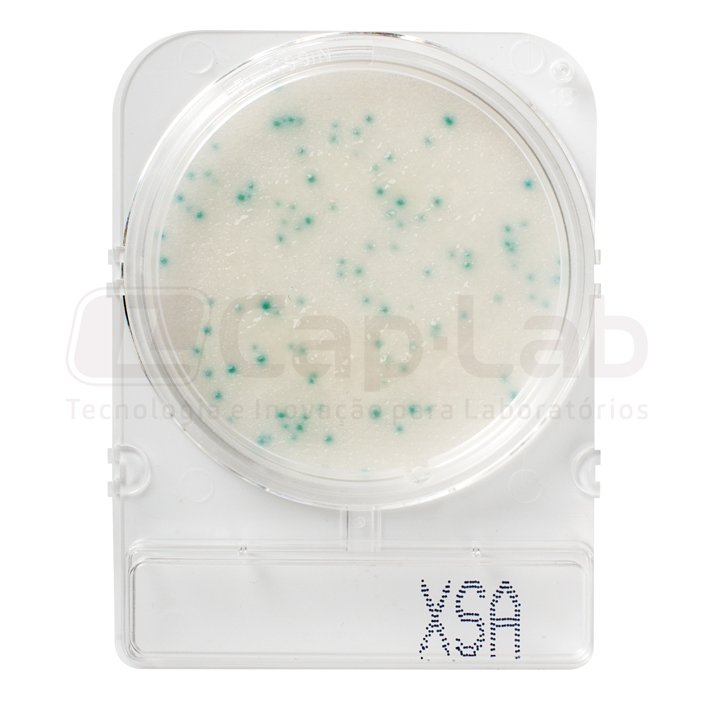

Compact Dry X-SA
Staphilococcus aureus
Incubação: 24 ± 2h
Temperatura: 35 ± 2°C
Descrição:
Compact Dry é um procedimento simples e seguro para determinar e quantificar microorganismos em produtos alimentícios, cosméticos e outras matérias-primas, incluindo produtos farmacêuticos. As placas cromogênicas Compact Dry prontas para uso são adequadas para os controles a serem realizados durante o processo e para os do produto final.
Especificações:
| Matriz: | Exposições de alimentos e superfícies |
| Tempo de incubação: | 24 ± 2h |
| Temperatura de incubação: | 35 ± 2°C |
| Embalagem: | 40 e 100 placas |
Modo de uso:
- Retirar a tampa
- Coloque 1 ml da amostra no centro da superfície da placa Compact Dry.
- A amostra é automaticamente dispersa de forma homogênea e hidrata a camada de meio de cultura, transformando-o em gel em poucos segundos.
- Tampe a placa novamente e inicie a incubação.
Interpretação de resultados:
As colônias de Staphylococcus Aureus exibem uma cor azul clara e somente essas devem ser contadas. Outras bactérias, além de S. aureus, podem crescer e formar colônias brancas e / ou roxas vermelhas; no entanto, apenas colônias azuis claras devem ser contadas. Observou-se que outras bactérias, especialmente as do gênero Bacillus, podem crescer e exibir colônias azul / azul claro; no entanto, essas colônias são facilmente diferenciadas das de S. aureus porque quase todas são maiores em diâmetro, “fosco” e achatado.
Armazenamento e prazo de validade:
- Manter em temperatura ambiente, de 1 a 30ºC.
- 18 meses de validade.